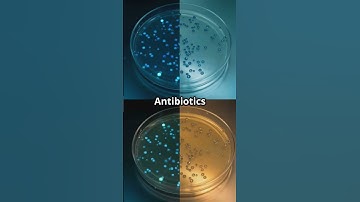
The Fight Against Superbugs #healthawareness #science #transformyourlifetoday

⬇ DOWNLOAD NOW
Kalau muncul iklan pop-up, tutup lalu klik tombol kembali
Download lagu Operation Superbug YouTube secara gratis hanya untuk keperluan promosi. Dukung artis favorit kamu dengan membeli musik original di iTunes atau platform resmi lainnya.
 STRONG ANTIBIOTIC = SUPERBUG
STRONG ANTIBIOTIC = SUPERBUG
 Antibiotic-Resistant Superbugs
Antibiotic-Resistant Superbugs
The Fight Against Superbugs #healthawareness #science #transformyourlifetoday
The Fight Against Superbugs #healthawareness #science #transformyourlifetoday
 The Silent Superbug War
The Silent Superbug War
 New Superbug Slayer Antibiotic Discovered! 💊🔥
New Superbug Slayer Antibiotic Discovered! 💊🔥
 AI Discovers New Antibiotic to Fight Superbugs
AI Discovers New Antibiotic to Fight Superbugs
 🦠 Superbug Threat? 💊 Next Pandemic Could Be Untreatable! ⚠️ | #TarachakraGlobal
🦠 Superbug Threat? 💊 Next Pandemic Could Be Untreatable! ⚠️ | #TarachakraGlobal
 Google's new AI solves superbug problems in two days - human researchers needed a decade
Google's new AI solves superbug problems in two days - human researchers needed a decade